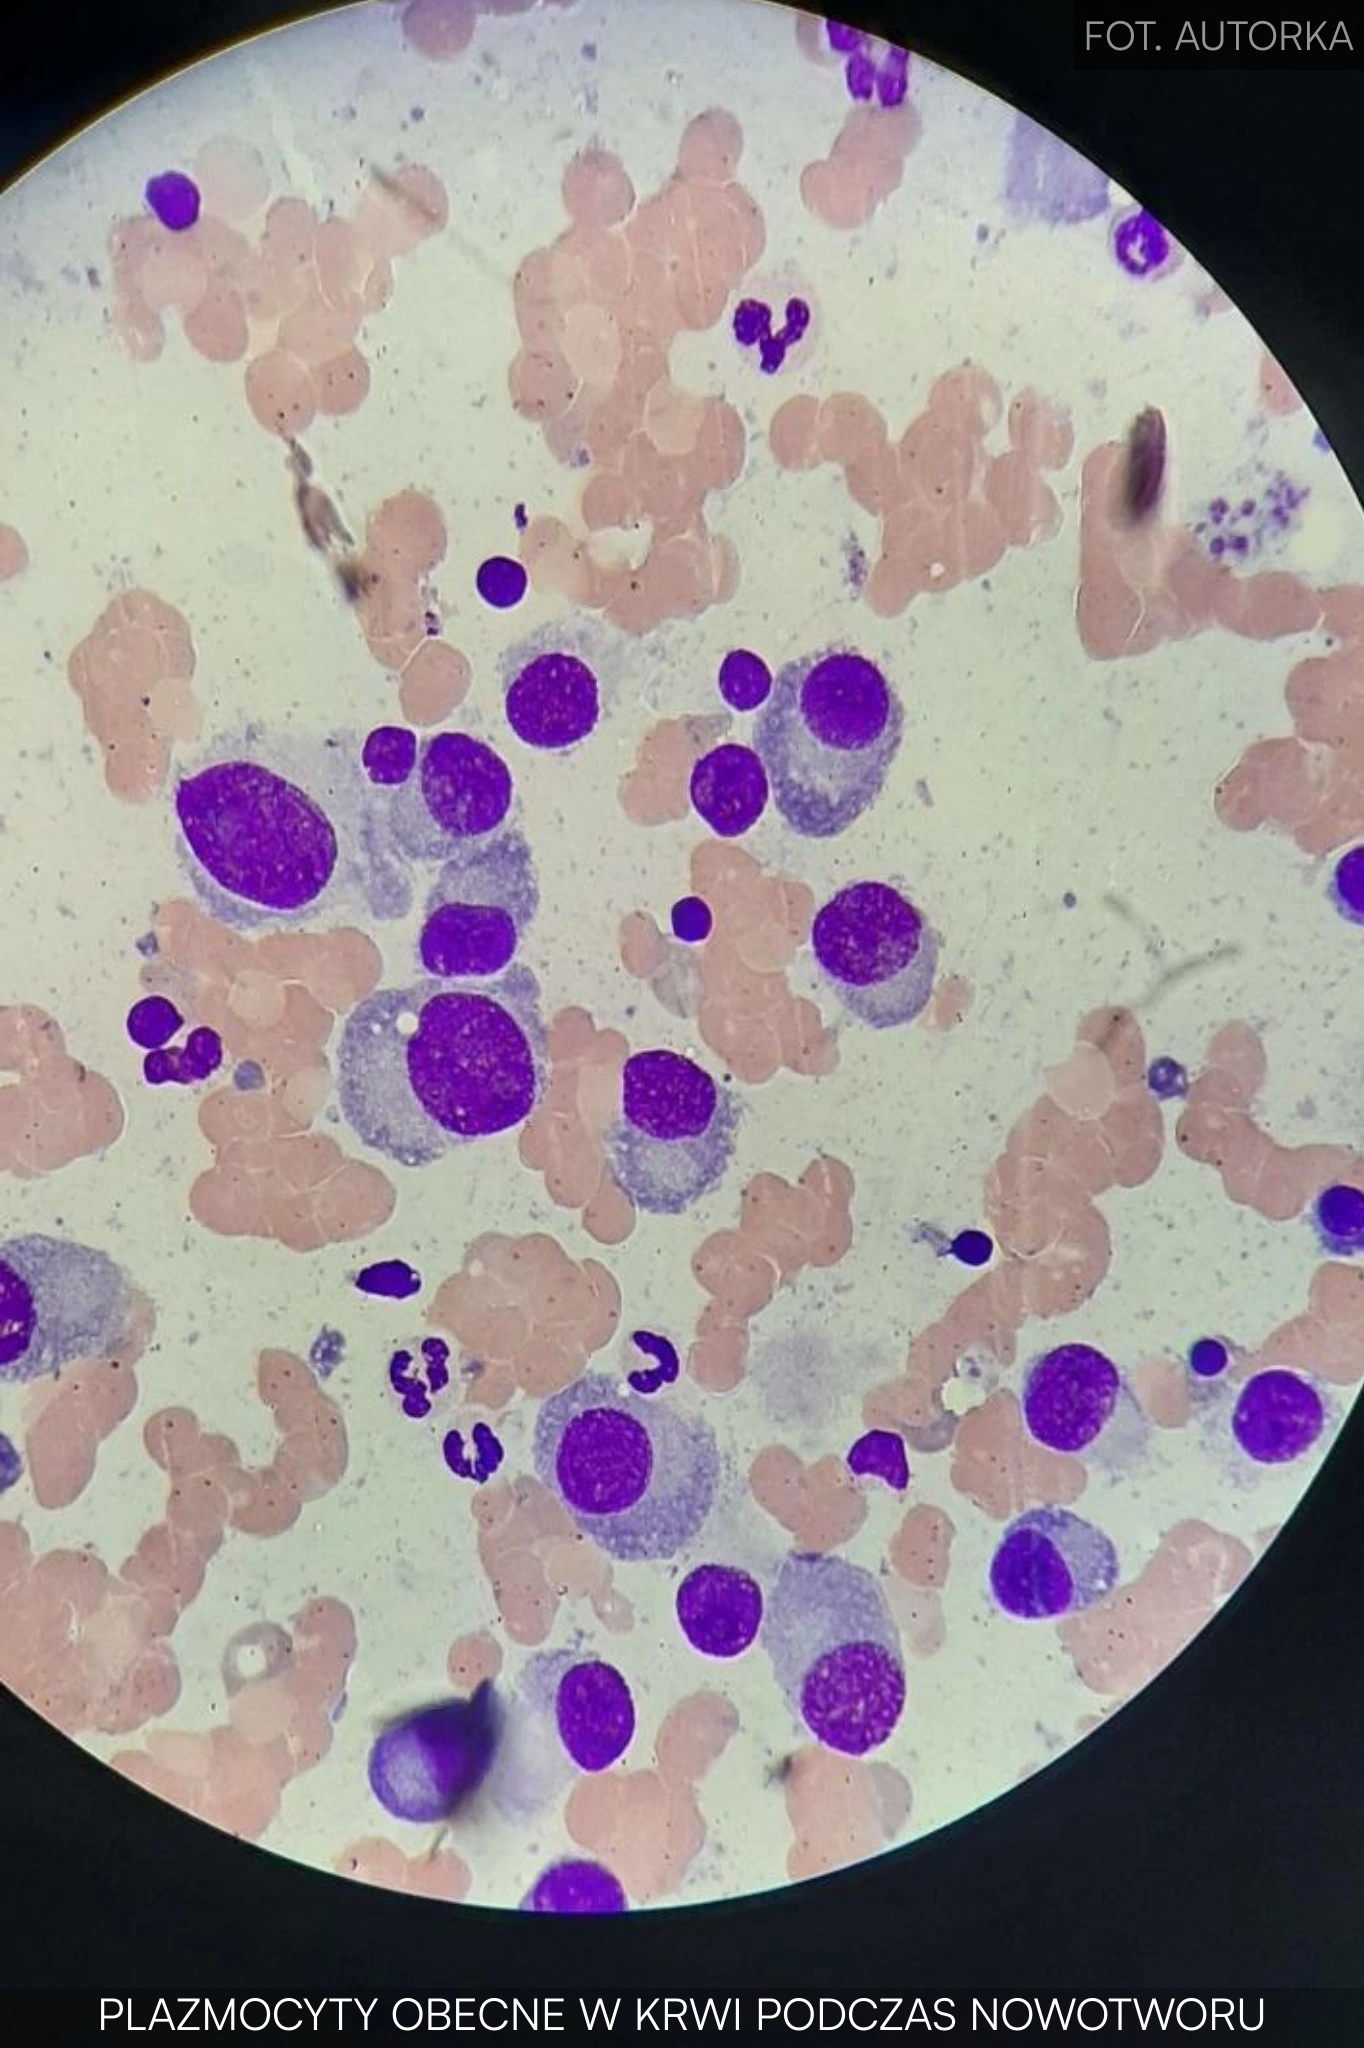

Dzień na 12-godzinnym dyżurze podczas miesiączki. Majtki menstruacyjne w laboratoryjnej rzeczywistości.
autor_ka:
Lucyna
Jakże ironicznie – jestem specjalistą w cytogenetyce hematologicznej. Krew w próbkach, krew w gaciach. W laboratorium króluje zapach krwi i octu. Na dyżurach pracujemy po 12 i 24 godziny. Pierwszy dzień okresu jest u mnie tym najgorszym – a próbki nie mogą czekać…

- Kiedy miesiączka przychodzi w najmniej odpowiednim momencie
- Praca w laboratorium, tam gdzie majtki menstruacyjne są niezastąpione
- Dlaczego jednorazowe podpaski i tampony odpadają?
- Zostają majtki menstruacyjne i kubeczek menstruacyjny
- Kiedy dzień się nie kończy o 20:00
- Porównanie majtek menstruacyjnych: Ora, Wielorazówka i CLARK
- Majtki menstruacyjne CLARK – pierwsze rozczarowanie
- Majtki menstruacyjne Wielorazówka – w porządku, ale nie na cały dzień
- Majtki menstruacyjne Ora – najlepsza opcja (jak dotąd)
- Podsumowanie
Poznaj autorkę
Wiek: 24 lata
Wykonywany zawód: Analityk medyczny z zawodu, pracownik ochrony zdrowia na stanowisku cytogenetyka klinicznego
Czy Twoje pierwsze doświadczenie z menstruacją było pozytywne, negatywne, czy neutralne?
Dość negatywne. Pierwszą miesiączkę dostałam wcześnie, nikt mnie też nie poinformował, że coś takiego występuje fizjologicznie, myślałam, że umieram.
Opisz w kilku zdaniach, jak zazwyczaj przebiega Twój cykl menstruacyjny:
Nieregularny cykl, obfite krwawienia, częste skrzepy i przedłużony cykl (w zależności od miesiąca czasem aż 6 dni miesiączki).
Jakie produkty menstruacyjne zazwyczaj używasz:
Kubeczek menstruacyjny w połączeniu z majtkami menstruacyjnymi. Jeśli okres mnie zaskoczy, zdarza mi się pożyczyć od kogoś podpaskę.
Notatki z okresu
Teksty w tej serii są pisane przez użytkowniczki produktów menstruacyjnych Ora.
Artykuły opierają się na osobistych, subiektywnych doświadczeniach i nie stanowią porad medycznych ani uniwersalnych rekomendacji.
Każdy tekst jest indywidualną perspektywą autorki i nie musi odzwierciedlać doświadczeń innych ani stanowiska marki.
Kiedy miesiączka przychodzi w najmniej odpowiednim momencie
Ponieważ mam dość nieregularną miesiączkę, zawsze szykuję sobie w każdym miejscu, w którym przebywam dłużej (praca lub dom), środki menstruacyjne. Tym razem nie miałam żadnych poprzedzających objawów, zauważyłam go dopiero na wizycie w toalecie. Na szczęście miałam już naszykowane majtki menstruacyjne w szafce.
Na dyżurach w moim zakładzie pracy mamy różne formy dyżurowania, ale z grubsza są to zmiany po 12h i 24h. Czasem zdarzało się więcej godzin pod rząd. Mi akurat wypadł dyżur 12-godzinny tego dnia. Następny dzień miałam mieć wolny, ale pierwszy dzień okresu jest u mnie tym najgorszym.
Praca w laboratorium, tam gdzie majtki menstruacyjne są niezastąpione
Próbki z Krakowa przyjechały już o godzinie 10:00, co oznaczało, że nie będzie czasu ani na zmianę majtek menstruacyjnych, ani nawet na wypicie herbaty, bo zaraz zjawią się próbki z innych miast.
Jakże ironicznie – jestem specjalistą (początkującym, ale staram się w tym rozwijać) w cytogenetyce hematologicznej, czyli układaniu chromosomów pozyskanych z białych komórek znajdujących się w krwi osób chorych na nowotwory. Także krew w próbkach, krew w gaciach. Ciężko nawet określić, czy czuć zapach krwi menstruacyjnej podczas korzystania z majtek menstruacyjnych, w naszych pracowniach króluje zapach krwi i octu, którego w połączeniu z alkoholem używamy do konserwacji.
Dlatego liczy się przede wszystkim komfort i chłonność. Praca zarówno siedząca, jak i stojąca. Stoję przy stole wykonując hodowle, barwiąc preparaty już na szkiełkach, a siedzę na krześle układając chromosomy w kariotyp najbardziej prawdopodobny. Każdy, kto widział chromosomy hematologiczne, będzie wiedział, o czym mówię.


Dlaczego jednorazowe podpaski i tampony odpadają?
W warunkach naszej pracowni jednorazowe podpaski nie mają racji bytu, szybko zachodzą wilgocią, a przy zmianach pozycji, no cóż, nie są najprzyjemniejsze. W specyfice pracy zawiera się także to, że takich pracowni jest mało, więc obrabiamy dziennie mnóstwo próbek, wydajemy blisko 140 wyników. Doświadczony cytogenetyk układa jedną metafazę, czyli komplet chromosomów, w około 5 minut. Do wydania wyniku układamy od 20 do nawet 100 metafaz, jeśli mamy wątpliwości.
Podsumowując – mnóstwo pracy. Są na to pewne normy, ale ciężko je stosować z uwagi na złożoność pracy. To prowadzi do kolejnej konkluzji: tampony z uwagi na częstą potrzebę zmiany (max co 4 godziny zgodnie z zaleceniami producentów) też się nie sprawdzą. Co prawda nikt nam nie wydziela wizyt w toalecie, ale próbki nie mogą stać zbyt długo, a jechały do nas czasem około 6 godzin, nie zostały też pobrane i wysłane od razu. Zazwyczaj jest to już około 8 godzin. Jeśli chcemy, żeby coś z nich było już w tej hodowli, musimy działać.

Zostają majtki menstruacyjne i kubeczek menstruacyjny
Więc zostają nam dwie formy: majtki menstruacyjne i kubeczek menstruacyjny. Z uwagi na to, że jestem nieródką, a także mam bardzo obfite okresy, kubeczek menstruacyjny sprawdza mi się super, ale nie na dyżurach. Około 15:00 zakładamy ostatnie hodowle, co daje około 5 godzin bez wizyty w łazience. Na upartego szybkie sikanie mogłoby wpaść pod warunkiem, że zdążymy w około 3 minuty wirowania: pójść, zrobić swoje, umyć ręce, wrócić i ubrać rękawiczki. Nie brzmi to jednak zbyt realistycznie.
Kiedy dzień się nie kończy o 20:00
Mój dyżur kończy się około 20:00. Pierwszego dnia okresu zazwyczaj nachodzą mnie nudności i bóle. Muszę pilnować, by spodnie i bielizna nie były obcisłe, bo inaczej nie dam rady usiąść na krzesło. Czeka mnie teraz około 5 godzin układania chromosomów i przygotowanie dokumentacji z dzisiejszego dnia.
Robię sobie herbatę i biorę drugi komplet leków przeciwbólowych. Staram się unikać ich zażywania, ale nie mogę sobie na to pozwolić w pracy. W toalecie mogę też na szybko zetrzeć skrzepy z majtek menstruacyjnych.
Każda metafaza to nowa przygoda, mimo że teoretycznie to ten sam pacjent. Chromosomy mogą się na siebie nakładać, a także możemy spotykać się z kariotypem mozaikowym. Oznacza to, że mamy do czynienia z pacjentem z dwoma różnymi genotypami, najczęściej jednym poprawnym i drugim dysfunkcyjnym bądź niepełnym. Czasem mutacji nie jesteśmy w stanie zauważyć, należy wtedy zadzwonić do lekarza i prosić o zlecenia dodatkowych badań takich jak western blot. W skrócie używamy tego do szukania specyficznych regionów w chromosomach. Lepsze są sondy, ale są droższe, dlatego też rzadziej zlecane.
Mój dyżur zaraz się skończy, mogę się przebrać i zmienić majtki menstruacyjne. Niestety to dopiero po powrocie do domu, bo tutaj mam tylko jedną parę. W sumie nie zdarza się to rzadko, ale padam na twarz. W domu szybki obiad z wczoraj w mikrofali. Nie mam nawet ochoty się przebierać. Okres i 12-godzinna zmiana mnie wykończyły, idę spać jak stoję.
Majtki menstruacyjne i moja pościel przetrwały, zmieniam je dopiero rano po około 22 godzinach. Tak, wiem, niezbyt to higieniczne, ale okres ogólnie nie jest jakoś super higieniczny*.
Dopisuję to po zrobieniu prania – majtki menstruacyjne się doprały i posłużą kolejne okresy.
*Uwaga: noszenie tych samych majtek menstruacyjnych przez 22 godziny nie jest zalecane ze względów higienicznych. [dopisek od Ora]

Porównanie majtek menstruacyjnych: Ora, Wielorazówka i CLARK
Jako duża fanka bardziej ekologicznych rozwiązań, a także takich, które sprostają moim oczekiwaniom, chciałabym porównać kilka majtek menstruacyjnych różnych firm.
Majtki menstruacyjne CLARK – pierwsze rozczarowanie
Pierwszymi majtkami menstruacyjnymi, które zakupiłam, były te z CLARK. Cóż, na stronie napisali, że są polską firmą i że generalnie majtki menstruacyjne to cud miód. Skusiła mnie też cena, około 60 zł za parę [aktualizacja: w 2026 roku to już 95 zł za parę]. Całkiem ładny wygląd i przystępna cena.
Pierwszy zonk zaliczyłam, kiedy czekałam na ich dostarczenie. Był to prawie miesiąc. No ale trudno. Kolejny, gdy je odpakowałam. Koperta wyglądała jak te, w których odbiera się rzeczy z AliExpress. Same majtki menstruacyjne CLARK były zapakowane w plastikową torebkę ziplock (swoją drogą ona służy mi do dziś, w przeciwieństwie do tych majtek menstruacyjnych).
Materiał, z którego były wykonane, przypominał plastik albo spadochron. Mój chłopak zaśmiał się, że to spandex, ten materiał, w którym śmigają sportowcy. Materiały, z których były wykonane, to niemal w całości plastik i oczywiście uszyte wcale nie w Polsce. Szukając potem szczegółów o tej firmie, doczytałam, że uprawiają zwykły dropshipping, więc w sumie kupiłam przepłacony plastik z Chin.
No ale dałam im szansę, już zapłaciłam, nie było zwrotów, generalnie życie. Użyłam ich któregoś dnia już okresu. To, jak odparzyły mi tyłek i jak moje dupsko się w nich spociło, to poezja. Chciałabym napisać o nich coś miłego, ale po pierwszym praniu wyszło z nich sporo nitek, a materiał na koronce się skulkował, więc nie były już nawet ładne. Nie wiem, co w sumie z nimi zrobić, bo nie wyrzucę ich, oddać też nie oddam.

Majtki menstruacyjne Wielorazówka – w porządku, ale nie na cały dzień
Kolejny wybór, już rok po pierwszym trafie, padł na Wielorazówkę. Majtki menstruacyjne były droższe, ale cóż, co bawełna to bawełna. Majtki menstruacyjne z Wielorazówki nosiło się o niebo lepiej, ale nie było mowy o noszeniu ich cały 12-godzinny dyżur pierwszego czy drugiego dnia. Idealnie sprawdzały się za to na końcowe dni miesiączki, a także na dni płodne, kiedy mam morze śluzu w majtach i majtki menstruacyjne to wybawienie.
Majtki menstruacyjne z Wielorazówki nie odparzyły mi tyłka i dobrze leżały, na skali do 10 dostałyby 8. Może nie były super piękne, ale zdawały egzamin. Noszone do kompletu z kubeczkiem menstruacyjnym w pierwsze dni dawały radę.
Majtki menstruacyjne Ora – najlepsza opcja (jak dotąd)
Majtki menstruacyjne Ora wypróbowałam stosunkowo niedawno, bo piszę to na świeżo po okresie. Na skali do 10 dałabym im 9,5. Pół punktu odjęłam za grubość wkładki, przez to jest w nich cieplej, co zimą byłoby plusem, ale w taką pogodę jak teraz (czyli gorąco, żar się z nieba leje) najchętniej pod fartuchem nosiłabym kostium kąpielowy.
Materiał znów bawełna, nie odparza, dobrze leży, ma certyfikat GOTS jak Wielorazówka. No czuć tę jakość. Dają sobie radę samodzielnie w pierwszy dzień (najbardziej chłonne bokserki), a także drugi (wysokie hipstery). Para najmniej chłonna posłużyła mi na dni płodne jeszcze przed okresem.
Podsumowanie
Mam porównanie tylko z trzech firm (Ora, Wielorazówka i CLARK), bo zwyczajnie taka jedna para majtek menstruacyjnych jest dość kosztowna, a zawsze staram się analizować, żeby nie utopić pieniędzy, a potem płakać. Co, jak widać, nie zawsze wychodzi, bo utopiłam na pierwszej parze CLARK.
Dziękuję, że przeczytałaś/eś artykuł Ora do końca.
Bądź na bieżąco! Zapisz się na prasówkę 📩, obserwuj Ora na Instagramie, Facebooku lub tik-toku.
Zastrzeżenie dotyczące bloga
Treści publikowane na tym blogu opierają się na dostępnych badaniach i informacjach w momencie ich tworzenia. W miarę pojawiania się nowych danych będziemy aktualizować nasze treści.
Zawarte tu treści nie stanowią porady medycznej. W przypadku jakichkolwiek problemów zdrowotnych zalecamy konsultację z lekarzem.
data dodania:
| aktualizacja:

